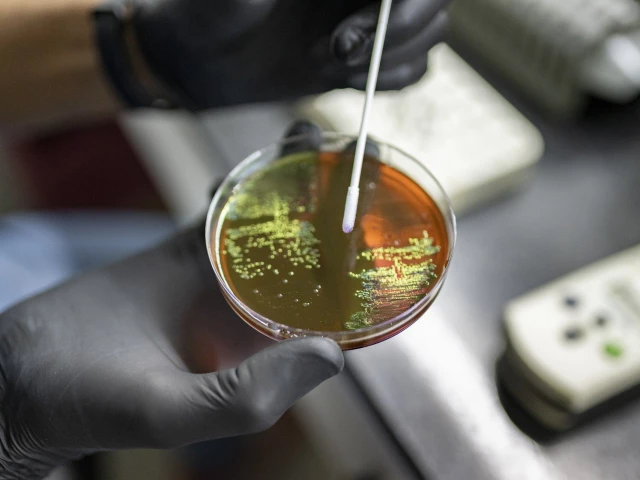

WHO warns against drug-resistant superbugs
.
There are not enough new tests and treatments in the pipeline to tackle the growing spread of drug-resistant bacteria, the World Health Organization warned Thursday.
The WHO says the increasing prevalence of antimicrobial resistance (AMR) — particularly the growing resistance of harmful bacteria to antibiotics — is one of the top global public health threats, and is thought to cause more than a million deaths annually.
The UN health agency says the misuse and overuse of antimicrobials — including antibiotics, antivirals and antifungals — in humans, animals and plants are the main drivers of drug resistance, with AMR having a disproportionate burden in low- and middle-income countries.
In twin reports on new tests and treatments for bacterial infections, the WHO warned far too little was in development.
"Antimicrobial resistance is escalating, but the pipeline of new treatments and diagnostics is insufficient to tackle the spread of drug-resistant bacterial infections," said WHO assistant director-general Yukiko Nakatani.
"Without more investment in research and development, together with dedicated efforts to ensure that new and existing products reach the people who most need them, drug-resistant infections will continue to spread."
AMR is defined by the WHO as occurring when microorganisms such as bacteria, viruses and parasites no longer respond to antimicrobial drugs.
'Dual crisis'
The WHO began tracking the development of antibacterial agents in 2017.
Since then, 17 new antibacterial agents against priority bacterial pathogens have obtained market authorisation. In its last update in 2023, there were 97 antibacterials in the clinical pipeline — those being tested on humans.
That number has now dropped to 90, the WHO warned.












1729471601-0/image-(8)1729471601-0-208x130.webp)






COMMENTS
Comments are moderated and generally will be posted if they are on-topic and not abusive.
For more information, please see our Comments FAQ